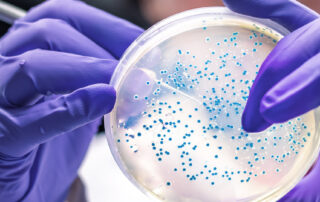

MAGAZINE
How much do healthcare-associated infections affect healthcare facilities?
Hospital-associated or healthcare-associated infections (HAIs) are infections that occur during or after a patient's [...]
Infections in hemodialysis patients: the ideal disinfection prophylaxis in the clinical setting
The topic of disinfection processes has always been central to prevention in the health [...]
Antibiotic resistance: what is it?
As the world continues its efforts against the Sars-CoV-2 virus, one cannot forget "superbugs," [...]
Antibiotic resistance on the rise: a trend to be reversed with prevention
One of the most serious consequences that the Covid-19 pandemic has brought with it [...]
Infectious diseases in prisons
The Covid-19 pandemic has highlighted how the spread of the virus is facilitated in [...]
Maxibios: let’s discover the device
Maintaining food safety in the food industry is of great importance and should not [...]